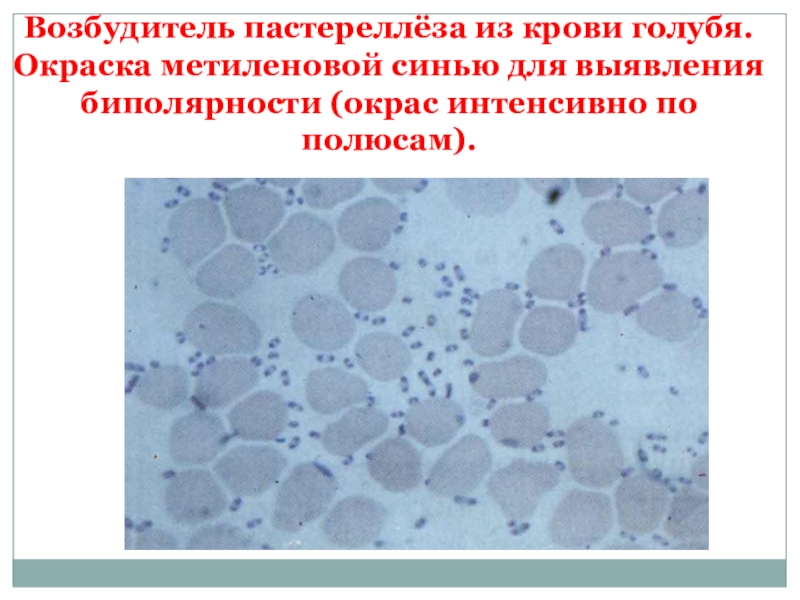
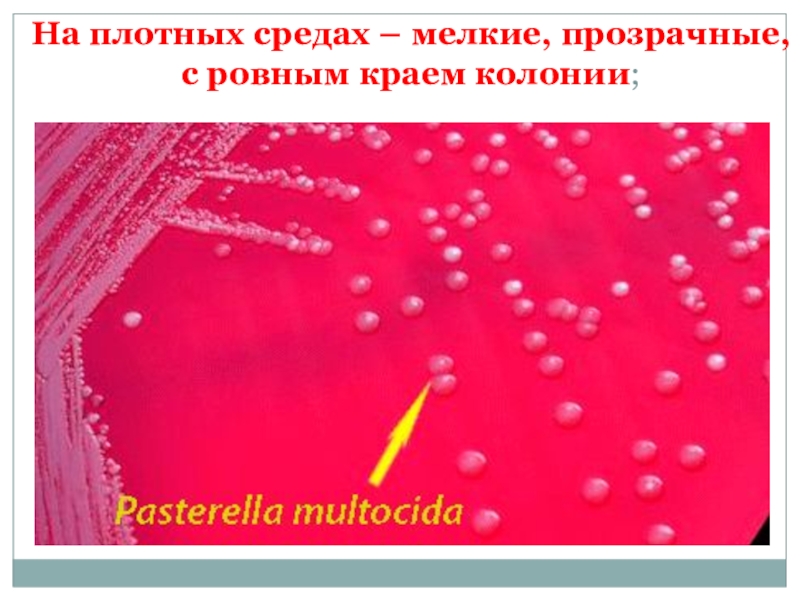

Слайд 11.Историческая справка
2. Возбудитель болезни
3. Эпизоотологические данные
4. Патогенез
5. Течение и клиническое
проявление
6. Патологоанатомические признаки
7. Диагностика и дифференциальная диагностика
8. Лечение
9. Иммунитет
10. Профилактика
и меры борьбы
Пастереллёз животных
Слайд 2Боллингер (1878) описал пастереллёз у КРС, Китт (1885) выделил возбудителя.
В
эти годы Пастер осуществил иммунизацию птиц, в честь его возбудитель
назван пастереллой, а заболевание – пастереллёз.
в 1939 г. Розенбушу и Мерганту описали возбудителя болезни как самостоятельный вид - Pasteurella multocida.
Существует самостоятельный вид Р. haemolutica
Историческая справка пастереллеза 1878-1887 гг.
Слайд 3Определение болезни
Пастереллез – инфекционная болезнь, характеризующаяся септицемией, воспалительно-геморрагическими процессами
во внутренних органах, на серозных и слизистых оболочках.
Слайд 4Возбудитель болезни
Сем.: Pasteurellaceae
Род: Pasteurella
Вид: Р. мultocida
Вид Р. haemolytica
Слайд 5P. мultocida, Р. Haemolutika- морфологические свойства
полиморфные;
чаще короткие;
грамотрицательные;
неподвижные эллипсовидные
палочки;
в мазках располагаются изолированно, парами или реже цепочками;
спор не
образуют;
образуют капсулу.
Слайд 6Возбудитель пастереллёза из крови голубя. Окраска метиленовой синью для выявления
биполярности (окрас интенсивно по полюсам).
Слайд 7Кокковидные палочки, расположенные одиночно, попарно, реже цепочками.
Грамотрицательные.
Слайд 8Культуральные свойства
Посев на питательные среды: МПА и МПБ с сывороткой
крови.
Особенности выделения культуры:
факультативные анаэробы;
оптимальная температура 37°;
срок культивирования 18-20 ч.
Слайд 9На плотных средах – мелкие, прозрачные, с ровным краем колонии;
Слайд 10На жидких средах – умеренное помутнение, на дне слизистый осадок,
при встряхивании поднимается в виде «косички».
Слайд 11Устойчивость возбудителя невысокая
В навозе, крови, холодной воде в течение
2-3 недель;
в трупах — до 4 месяцев;
в замороженном мясе
—- в течение 1 года.
Губительно
Прямые солнечные лучи - несколько минут;
Т 70-90 °С 5-10 минут.
5%-ный раствор карболовой кислоты - 1 минута;
5%-ный раствор гидроксид кальция— через 4-5 минут;
3%-ный горячий раствор (50 °С) гидрокарбоната натрия и 1%-ный раствор хлорной извести — через 3 минуты.
Слайд 12Эпизоотологические данные.
Восприимчивы - все виды домашних и диких млекопитающих животных,
птиц (холера птиц) и человек.
Устойчивы – плотоядные и лошади.
И.И.
больные и переболевшие животные – носители пастерелл – больше года.
Для пастереллёза свойственно носительство возбудителя здоровыми животными.
Поэтому вспышки возникают в результате воздействия на животных неблагоприятных факторов.
Слайд 13Особенность пастерелёза - энзоотичность и стационарность.
Стресс-факторы:
неполноценное кормление (недостаток
витаминов, аминокислот, микроэлиментов);
неудовлетворительное условие содержания (холод, дождь, сквозняк и
т.д.).
Слайд 14Патогенез
Заражение – респираторно и алиментарно, возможно через поврежденные покровы.
Возбудитель
на месте проникновения размножается и проникает в кровь и лимфу,
вызывая септицемию;
Эндотоксины и агрессины повреждают стенки сосудов, вызывая массовые кровоизлияния, появляются отеки в подкожной и межмышечной клетчатке. Геморрагический диатез.
Все это приводит к омертвлению тканей.
Слайд 15Течение и клиническое проявление
Инкубационный период от нескольких часов до 3
суток.
Течение - сверхострое, острое, подострое, хроническое.
Слайд 16У КРС и буйволов
Сверхостро - внезапно Т - до 41
°С, иногда кровянистый понос.
Гибель наступает через несколько часов от
сердечной недостаточности и отека легких.
Острое - характеризуется кишечной , грудной либо отечной формой течения .
Кишечная форма чаще проявляется у молодняка и характеризуется прогрессирующей диареей (кровянистый понос). Слабость, жажда, анемичность слизистых оболочек и нарастающее угнетение.
Грудная форма - острая фибринозная плевропневмония: затрудненное дыхание, кашель, серозные и серозно-гнойные истечения из носовых отверстий. Нередко развивается диарея с примесью крови. Заболевание длится несколько дней. Животные погибают, либо болезнь принимает подострое или хроническое течение.
Отечная форма - воспалительные отеки подкожной клетчатки и межмышечной соединительной ткани в области головы, шеи, подгрудка, срамных губ, а иногда конечностей. Слизистая рта, язык отечны, синюшные. Дыхание хрипящее. Из угла рта выделяется тягучая слюна. Гибель при явлениях нарастающей сердечной недостаточности и асфиксии.
Слайд 19У овец
Острое течение с признаками септицемии встречается редко. (Лихорадка, отеки,
фибринозная плевропневмония, гибель на 2-й – 5-й день).
Подострое и
хроническое течения характеризуются затяжной фибринозной плевропневмонией, кератитами, слизисто-гнойным ринитом, артритами и прогрессирующим истощением.
Слайд 20У свиней
Встречается в виде вторичной инфекции, осложняющей чуму, грипп,
рожу и др. болезни.
Острое, как самостоятельная инфекция, характеризуется явлениями
геморрагической септицемии и поражением легких и плевры.
Сверхострое течение – Т до 41-42 °С. Свиньи лежат, отказываются от корма. Кожа ушных раковин и брюшной стенки становится синевато-багровой — признак сердечной недостаточности. Развивается фарингит, подкожная клетчатка в области шеи сильно отекает. Асфиксия в течение 1-2 суток.
При подостром выступают признаки фибринозной пневмонии: кашель, одышка и слизисто-гнойный ринит, смерть на 5-8-й день.
При хроническом - температура в пределах нормы, слабость и исхудание прогрессируют, появляются экземы, опухают суставы. Некоторые животные выживают, но большинство погибают через несколько недель.
Слайд 21Поза сидячей собаки у свиней при пастереллёзе
Слайд 24У кроликов
Чаше проявляется остро, реже наблюдают подострое и хроническое течение.
При остром течении – Т до 41 °С и выше.
Признаки катара верхних дыхательных путей — насморк, чихание. Дыхание затрудненное. Появляется диарея. Через 1-2 суток может наступить смерть.
Подострое течение является результатом обострения хронического заболевания. Наблюдаются признаки бронхопневмонии, крупозной пневмонии, фибринозного плеврита. Часто бывает диарея.
Хроническое течение характеризуются признаками ринита, конъюнктивита и кератоконъюнктивита. Дыхание становится затрудненным. В подкожной клетчатке можно обнаружить абсцессы.
Слайд 26Холера птиц протекает по-разному.
Иногда погибает совершенно здоровая на вид
птица. Лишь перед самой смертью отмечают угнетение общего состояния и
посинение гребня.
Острое течение – птица вялая, держится отдельно, сидит на одном месте, изо рта и носовых отверстий вытекает много пенистой слизи. Т - до 43,5 °С, перья взъерошены, тусклые. Фекалии серого, желтого или зеленоватого цвета, иногда с примесью крови. Цианоз гребня и сережек. Дыхание затрудненное. Аппетит отсутствует, жажда, слабость, гибель через 3 дня.
Слайд 29Патологоанатомические признаки.
У КРС кровоизлияния на серозных оболочках, увеличение и отечность
лимфоузлов, геморрагический гастроэнтерит, селезенка не увеличена. Отек в области головы
шеи, подгрудка, половых органов и заднепроходного отверстия. Отмечают дистрофические изменения в печени, почках и сердце.
При грудной форме изменения в области легких: некротизирующая пневмония и плевропневмония отдельных участков легких, а иногда и целых долей. Крупозная пневмония отличается от классической — мраморность неотчётливая, в экссудате много эритроцитов, быстро возникают некротические фокусы — тусклые, грязно-сероватого или темно-коричневого цвета, величиной от горошины до кулака. Регионарные лимфоузлы увеличены, сочные, с точечными кровоизлияниями.
Слайд 30У овец - кровоизлияния в подкожной клетчатке, мышцах, на серозных
оболочках, лимфатических узлах, кишечнике и сердце. Легкие обычно увеличены, синюшные,
в трахее скапливается пенистая жидкость.
У свиней при остром обнаруживают многочисленные кровоизлияния на коже, серозных и слизистых оболочках, студенисто-серозный отек подкожной клетчатки в области гортани и шеи, отек легких, увеличение и гиперемию лимфатических узлов.
Хроническом течении сильное уплотнение ткани легких, на разрезе они имеют пестрый вид. В легких находят различной величины безвоздушные плотные участки.
Слайд 33У кроликов
При гибели при остром течении - многочисленные кровоизлияния
на слизистой оболочке верхних дыхательных путей, в лимфатических узлах, на
слизистой и серозной оболочках кишечника. Особенно характерными считаются полосчатые кровоизлияния между кольцами трахеи.
Легкие гиперемированы, отечны, усеяны точечными кровоизлияниями.
При подостром течении - фибринозный или гнойный плеврит, крупозно-геморрагическую пневмонию.
При хроническом - наличие абсцессов под кожей, в лимфатических узлах, в молочной железе, во внутренних органах. Воспалена слизистая оболочка желудка и кишечника. В легких и печени могут быть мелкие некротические очаги.
Слайд 35У птиц
При сверхостром течении пастереллёза изменения в трупах обычно отсутствуют.
При острогом течении - геморрагии подкожной клетчатки. Сердечная сумка наполнена
экссудатом. Сердце покрыто многочисленными геморрагиями и кажется как бы забрызганным кровью. Признаки энтерита, особенно 12-перстной кишки. В брюшной полости - экссудат. Печень желтоватого цвета, плотной консистенции, покрыта точечными сероватыми некротическими очажками. Селезенка обычно не изменена.
При хроническом и подостром - гребень и сережки посиневшие, грудная мускулатура окрашена в темный цвет, кровоизлияния на эпикарде, на слизистой оболочке кишечника, печень увеличена, с множественными мелкими очажками некротического характера. При артритах в опухших суставах скапливается творожистый гнойный экссудат.
Слайд 36Диагностика и дифференциальная диагностика.
Слайд 37Лечение
Больных животных помещают в теплые, сухие станки, обеспечивают полноценными
кормами и применяют антибиотики тетрациклинового ряда и сульфаниламидные препараты согласно
принятым наставлениям.
Использование сыворотки эффективно при остром течении в начале болезни. Её вводят внутримышечно или внутривенно в двойной профилактической дозе согласно наставлению.
Лечебный эффект заметно повышается при сочетании применении сыворотки с пролонгированными антибиотиками, сульфаниламидами и симптоматическими средствами. Курс лечения зависит от состояния животного.
Птиц, больных пастереллёзом, не лечат.
Слайд 38Биопрепараты для специфической профилактики.
Переболевшие животные приобретают иммунитет на 6
– 12 мес.
Полужидкая гидроокисьалюминиевая вакцина против пастереллёза (геморрагической септицемии) крупного
рогатого скота и буйволов.
Слайд 39Вакцины
инактивированная преципитированная вакцина (для овец и свиней);
инактивированная эмульгированная вакцина (для
кур, уток);
живые вакцины из штамма АВ и К (для всех
видов птиц).
Слайд 40Сыворотка против пастереллёза, сальмонеллёза, эшерихиоза, парагриппа-3, инфекционного ринотрахеита крупного рогатого
скота.
Слайд 41Обеспечивают охрану благополучных хозяйств от заноса возбудителя пастереллоносителями, а также
с кормами и т. п.
Соблюдение общих ветеринарно-санитарных правил и
обеспечение животных нормальными зоогигиеническими условиями содержания и рациональным кормлением.
Если ранее на фермах регистрировали заболевание, всех животных вакцинируют против пастереллёза в течении года.
Профилактика и меры борьбы
Слайд 42При установлении заболевания животных пастереллезом хозяйство (ферму, бригаду, отделение и
т.д.) объявляют неблагополучным по пастереллезу, решением территориальной администрации вводят ограничения
и утверждают план организационно-хозяйственных и ветеринарно-санитарных мероприятий по ликвидации заболевания.
Профилактика и меры борьбы
Слайд 43При ограничениях. Все поголовье обследуют клинически, больных и подозрительных по
заболеванию животных изолируют и лечат, а остальных вакцинируют против пастереллеза.
Проводят текущую дезинфекцию после каждого случая выделения больного животного и в последующем – через каждые 10 дней до снятия ограничения. Трупы животных утилизируют или сжигают.
Ограничения с хозяйства снимают через 14 дней после поголовной вакцинации животных и последнего случая заболевания при условии проведения заключительной дезинфекции.
Профилактика и меры борьбы
Слайд 44В неблагополучном по пастереллёзу хозяйстве запрещается:
ввозить (вывозить) за пределы хозяйства
животных для племенных и пользовательских целей, за исключением вывоза на
мясокомбинат клинически здоровых животных;
ввозить (вывозить) восприимчивых к пастереллезу животных;
перегруппировывать, метить (с нарушением кожи) животных, проводить хирургические операции и вакцинации против других болезней;
выпасать животных из неблагополучных групп и поить их из открытых водоемов;
реализовывать молоко от больных и подозреваемых в заболевании пастереллезом животных. Молоко пастеризуют - 5 минут при 90 °С и использовать в корм животным. Молоко от здоровых коров используется без ограничений;
выносить (вывозить) из помещений неблагополучных ферм корма, инвентарь, оборудование и другие предметы;
вывозить на поля навоз и жидкую фракцию в необеззараженном виде.
Слайд 45Задача 1. На молочной ферме имеется 300 коров. В июле
на пастбище внезапно заболели две коровы, одна из них пала,
вторую успели прирезать. При вскрытии у обоих животных обнаружили геморрагическую септицемию, студенистые инфильтраты и крупозную пневмонию. Предварительный диагноз — пастереллез.
При эпизоотологическом обследовании ферм установлено, что в стадо за 10 дней до вспышки болезни было переведено 50 животных с фермы, на которой уже два раза регистрировались вспышки пастереллеза. Последняя вспышка была 6 мес. назад. На данной ферме пастереллез не регистрировали.
Необходимо:
а) обосновать окончательный диагноз на пастереллез;
б) составить план мероприятий, предусматривающих оздоровление фермы от пастереллеза.
Слайд 46Задача 2. На свиноводческой ферме имеется четыре свинарника на 3200
свиней. В одном из них появилось заболевание свиней, быстро распространяющееся.
Животные переболевают очень тяжело и остро, с высокой температурой. У многих свиней в области подчелюстного пространства появляются отеки. Перед смертью у больных животных синеют уши, а затем и кожа живота. При вскрытии трупов отмечались геморрагический диатез, отеки в подкожной и субсерозной тканях, воспаление слизистой оболочки желудка.
Необходимо:
а) определить направление исследований для уточнения диагноза;
б) организовать лечение животных, больных пастереллезом;
в) разработать план оздоровительных мероприятий при пастереллезе и рассчитать потребность в необходимых биопрепаратах.